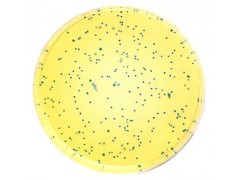

| 提交询价信息 |
| 发布紧急求购 |

价格:电议
所在地:上海
型号:
更新时间:2014-09-12
浏览次数:813
公司地址:上海市
![]()
霍经理(先生)
上海仁捷生物科技有限公司专业经营生产ELISA试剂盒,科研化试剂、分析试剂 ,代理许多国际先进水平的高科技产品,包括分子生物学、细胞生物学、免疫学、诊断等多个研究及应用领域。我们努力将欧美专业生产厂家的具有国际先进水平的产品推荐给各类研究人员;另一方面也非常重视自主产品研究和开发,推出了一系列具有竞争力的产品和服务。同时国家对于生物行业的发展给予了极大的重视,更多地侧重于科研的投入。
上海仁捷生物科技有限公司 霍 手机17302193538 QQ:2450878877 座机:021-60346444
上海仁捷生物科技有限公司 霍 手机17302193538 QQ:2450878877 座机:021-60346444
产品用途及说明:用于饮用水中异生细菌分离培养(ACUMEDIA方法)
包 装 :250
培养基配方举例 免责声明:以上所展示的[ R2A 琼脂]信息由会员[上海仁捷生物科技有限公司]自行提供,内容的真实性、准确性和合法性由发布会员负责。
免责声明:以上所展示的[ R2A 琼脂]信息由会员[上海仁捷生物科技有限公司]自行提供,内容的真实性、准确性和合法性由发布会员负责。